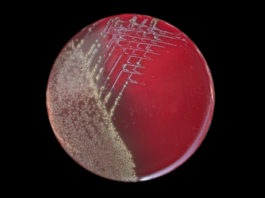
ANSA: vaccino pertosse causa contagio

SPECIALE VACCINI
DEPLIANT VACCINI – Libera Scelta
Rendiamo disponibile il depliant sui vaccini realizzato dal gruppo di Libera Scelta per sensibilizzare nuovi genitori. Questa brochure sui vaccini è un invito a...
Vaccini, Giustizia al servizio della Scienza
La Procura di Roma ha chiesto l’archiviazione di un'importante indagine sulla sicurezza dei vaccini per "sanare la frattura tra scienza e società". La FNOMCeO è...
Vaccini: Cassazione, niente risarcimento danni se procedura rispettata
« Nessuna responsabilità medica per danni neurologici provocati dal vaccino per la pertosse perché al momento della vaccinazione il bambino non presentava alcuna controindicazione....
VIDEO CONSIGLIATI
Vaccini e tumori, parla il candidato Nobel allievo di Sabin: Giulio...
Non servono presentazioni per il Prof. Tarro, virologo di fama internazionale, candidato al premio Nobel e allievo di Sabin (inventore del vaccino anti-polio). Ecco...
COMUNICATI STAMPA
SCUOLA E VACCINI
Vaccini COVID-19 e adolescenti: il parere del Comitato Bioetica
In vista della ripresa dell'anno scolastico il Comitato Nazionale per la Bioetica (CNB) si è espresso riguardo la necessità di vaccinare contro il Covid-19...
PARLAMENTO
VARIE
Nasce Libera Scelta – Liberascelta.org
Oggi nasce Liberascelta.org, sito aggregatore di notizie e informazioni utili per gli obiettori attivi e i sostenitori della libertà di scelta vaccinale, ma non...
LEGGE 210/92 – Indennizzo danneggiati da vaccinazioni
Evoluzione della Legge 210/92 e come fare domanda di indennizzo. Testo integrale ed elenco documentazione utile disposta dal sito Comilva.org.
LEGGE 210/92: "Indennizzo a favore...
12 vaccini obbligatori, sanzioni ed esclusione da asili
Su pressione del ministro della salute Beatrice Lorenzin, che di questo ha fatto una sua crociata personale, il Consiglio dei ministri ha dato l’ok...
Puglia: vaccini in cattedra!
Parte quest'anno il piano sperimentale di educazione alla vaccinazione nelle scuole pugliesi. L'iniziativa congiunta Scuola-Regione, ufficializzata con il protocollo d'intesa stipulato tra Regione Puglia e Uffici Scolastici,...
AVVISI DI SERVIZIO
Autismo, facebook: genitori in cerca di rimedi, segnalati ai servizi sociali
Una nuova moda prende piede nel folle mondo dei social: infiltrati che si iscrivono ai gruppi Facebook per segnalare ai servizi sociali genitori che...
AGENDA
CORTEO TORINO 23 marzo 2019 – LIBERTÀ DI SCELTA
GUARDA LO SPOT - Corteo "Vaccini: il cavallo di Troia", per difendere l'inviolabilità del corpo, ora e sempre. Tanti cittadini insieme contro i ricatti...